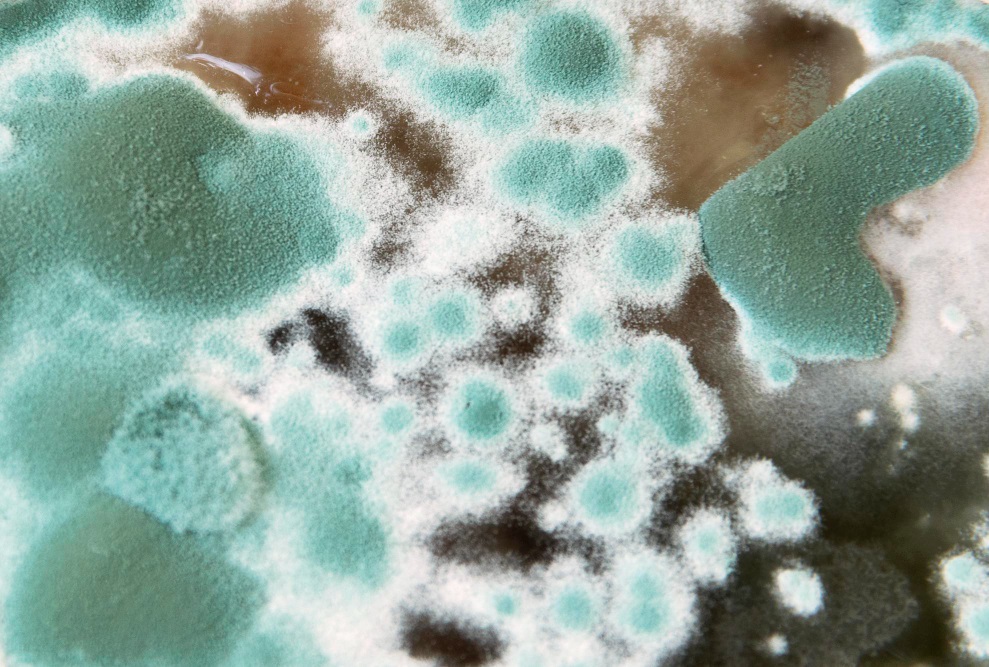

유해생물 – 먼지다듬이
유해생물
바퀴벌레
쥐
개미
먼지다듬이
기타해충
Customer Center
문의전화
1688-1475
궁금하신 사항 문의주세요.
항상 친절하게 답변해드립니다.

먼지다듬이
BOOKLICE
먼지다듬이는 몸길이 1~3MM 정도되는 미세곤충이다.
때문에 알의 이동이 용이하여 확산이나 번식력이 크다.

생존 적정 습도는 75~80% 정도이고, 먼지나 미세한 균, 곰팡이 등을 먹고 산다. 발생할 경우 정신적인 스트레스가 매우 심하고 천식이나 알러지를 유발한다는 보고가 있다.
주로 가구, 장판, 벽지 틈새에 몰려 서식. 사람에게 큰 피해를 주지 않지만 알레르기를 유발할 수 있다.
주요 서식처로는 습한 바닥, 배관틈새, 벽틈새, 화분주위, 목재가구류, 책이나 종이 사이, 적재된 종이 Box, 나무껍질 속, 해묵은 둘 표면,낙엽속 등지이다
본래 집으로 유입하는 해충이 아니고, 외부에서 들어온 물건들에 붙어서 집으로 들어오게 된다.
그러므로 외부에서 침구류나 옷 등을 구입했을 때는 되도록 세탁하여 보관하는 것이 좋다. 시중에서 판매되는 훈연제를 1주일에 한번씩 2회정도 사용하면 효과가 있다.
알에서 성충까지 약 1~2달 정도 소요되며 습하고 더운 곳을 선호한다.
이들은 주로 미세한 균류나 곰팡이를 먹고 자라므로 이들을 제거하는 것이 중요하다.
잡식성으로 균류, 꽂가루, 마른 식물, 곡물가루 또는 곤충의 시체 등이며 실내에서 서식하는 경우는 먼지도 섭취할 수 있다.